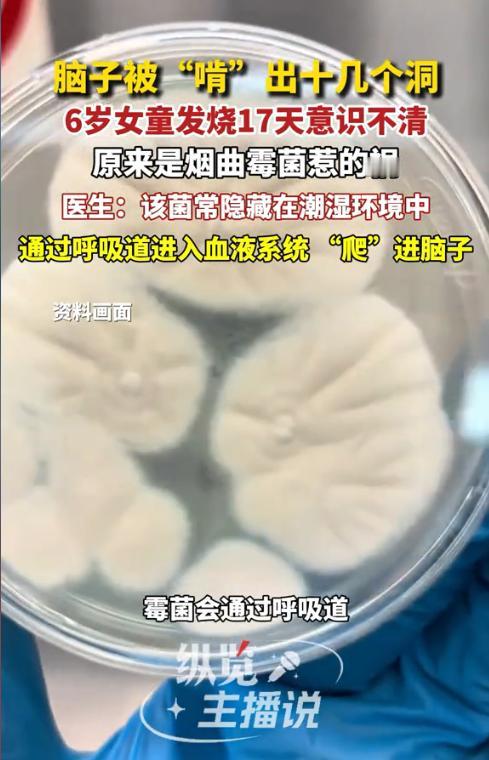

“太可怕了!”近日,河南,一6岁女孩连续几天高烧不退,吃了几天退烧药后仍不见好,连续高烧17天时,开始意识不清,家人紧急送往医院治疗,竟发现孩子脑袋里面被“啃”了十几个洞。医生:再晚点脑子都空了!
孩子发烧本是家长们常遇到的小状况,多数人会先按感冒处理,但持续不退的高烧往往是身体发出的危险警报。这位6岁女孩就因被当作普通感冒拖延,直到意识不清才就医,险些酿成悲剧。
据媒体1月16日报道,女孩起初只是出现发热症状,家人以为是普通感冒,就在家给孩子服用退烧药。但是接连几天也不见好。就在连续发烧17天后,孩子逐渐出现意识模糊、精神萎靡的情况,甚至最后连家人都认不清了。
察觉到不对劲的家长赶忙将孩子送往医院,经过详细检查,医生在她的脑部影像中发现了令人震惊的一幕——孩子的大脑组织被真菌“啃”出了十几个空洞。进一步检查后才发现罪魁祸首是烟曲霉菌。
医生解释,这种真菌通常隐藏在潮湿发霉的环境中,比如长期未清理的空调滤网、潮湿的墙角、腐烂的蔬果表面等。它会通过呼吸道进入人体,在免疫力较弱的孩子体内,真菌能突破呼吸道屏障进入血液系统,最终“爬”进大脑,侵蚀脑组织并形成脓肿和空洞,严重时可危及生命。
由此可见,看似不起眼的潮湿发霉环境,可能暗藏致命的健康隐患。网友看后纷纷表示,光是听着就头皮发麻,家里潮湿的地方必须马上清理,尤其是卫生间死角这些地方最容易发霉。
信息来源:《6岁女孩连烧17天,脑子竟被“啃”出十几个洞!》纵览新闻